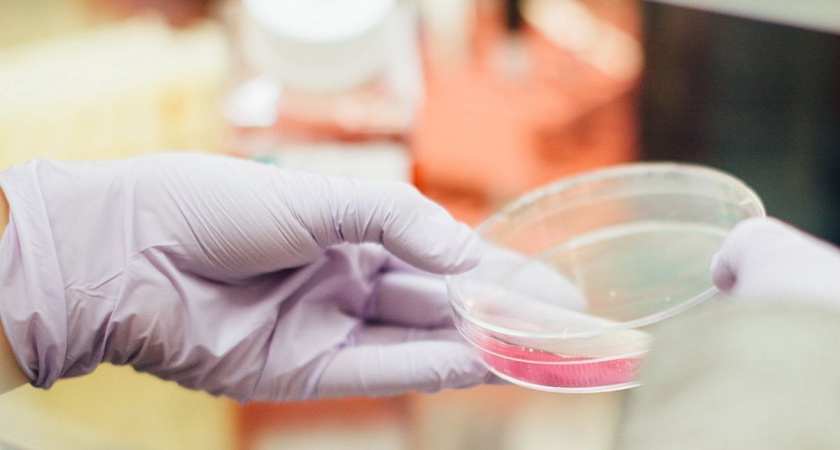

Микроскопические «пузырьки» против бактерий: кубанские ученые создали гель, который полностью очищает десневые карманы
- 21 октября 2025
- Александр Петров
В Кубанском государственном медицинском университете молодые исследователи разработали инновационный гель, предназначенный для терапии и профилактики заболеваний десен. Об этом сообщает издание Кубанские новости, ссылаясь на заявление руководителя регионального Минздрава Евгения Филиппова, сделанное 21 октября в его Telegram-канале.
Ключевая особенность этого лекарственного средства заключается в использовании передовых липосомальных технологий. Липосомы - это крошечные "пузырьки", способные удерживать внутри себя полезные вещества и способствовать их лучшему проникновению в организм. Гель, разработанный учеными медуниверситета, эффективно уничтожает патогенные бактерии в десневых карманах, способствует восстановлению поврежденных тканей и обеспечивает долговременную защиту зубов, - написал министр здравоохранения Краснодарского края.
Новый гель предполагается использовать в рамках фотодинамической терапии. Этот терапевтический подход включает нанесение на воспаленные десны особых составов, которые взаимодействуют со светом. После нанесения эти соединения активируются световым воздействием определенной длины волны, что позволяет устранять вредоносные бактерии и стимулировать восстановление десневых тканей.
Эта новая разработка демонстрирует повышенную эффективность по сравнению с традиционно применяемыми методами лечения.
В настоящее время продукт находится в процессе патентования. Разработчики активно готовят полный пакет технической документации и проводят все обязательные доклинические испытания.
Прогнозируется, что данный препарат будет внедрен в клиническую практику примерно через полтора года после успешного завершения всех необходимых испытаний и официальной регистрации.